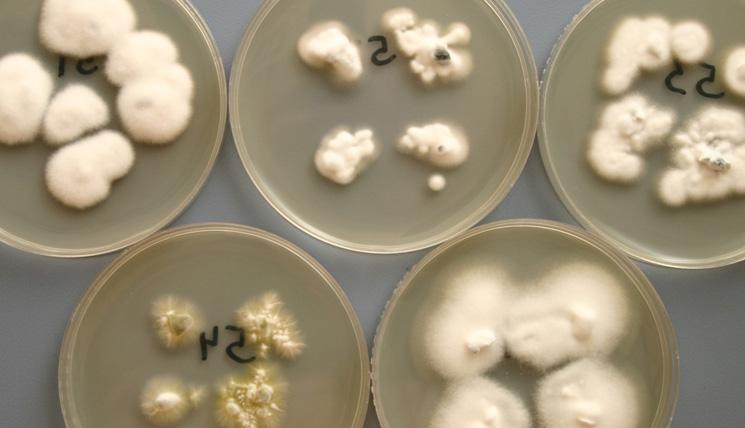

Gastbeitrag:
Zehnter Beitrag der Artikelreihe: Moderne Mykologie in der Dermatologie
von Herrn Prof. Hans-Jürgen Tietz, Leiter des Instituts für Pilzkrankheiten, Berlin
Der diesjährige zweite Ringversuch zum Thema „Dermatophyten, Hefen und Schimmelpilze“ ist nicht nur eine enorme Herausforderung für die Teilnehmer, sondern auch eine ernsthafte Prüfung der Leistungsfähigkeit der Gendiagnostik, der PCR: Ein in doppelter Hinsicht aufschlussreicher Stresstest.
Kein anderer Ringversuch in den letzten Jahren war derart anspruchsvoll und fordernd wie dieser. „Die sehen ja alle gleich aus“, war die erste Reaktion vieler Prüflinge. Auch ich muss gestehen, dass ich einen der Keime, Nannizzia persicolor, seit Beginn meiner Facharztbildung 1981, im richtigen Leben noch nie sah, außer in Stammsammlungen. Ich gebe ebenso zu, dass ich ohne die PCR den aktuellen Ringversuch nicht bestehen würde, trotz aller Erfahrung und Tricks in der konventionellen Pilzdiagnostik. Auf den Kulturmedien erwiesen sich die Keime als durchweg degeneriert, vier von fünf waren wie in Watte gepackt (s. Titelbild; Kulturen des Ringversuchs 2-2021 auf einem Dermatophytenagar). Was waren das noch für Zeiten als die Erreger in Schrägagar-Röhrchen versandt wurden und oft bereits per Blickdiagnose bestimmbar waren.
Doch mitnichten war früher alles besser. Im Gegenteil, die diesjährigen Stämme wuchsen durchweg gut und schnell an. Sie wurden zudem überwiegend von Kindern isoliert, was die aktuelle Situation auf dem Gebiet der Mykosen vortrefflich widerspiegelt. Vor allem während der Corona-Lockdowns haben sich Mykosen bei Kindern enorm verbreitet, insbesondere zoophile Arten wie T. mentagro-phytes, T. benhamiae oder T. quinckeanum, der Erreger des Mäusefavus, und ebenso der anthropophile Pilz T. interdigitale, womit alle im aktuellen Ringversuch vorkommenden Spezies genannt sind. Allein im letzten Jahr kamen in Deutschland eine Million Haustiere hinzu, vor allem Meerschweinchen. Auch die Hundesteuer stieg auf ein Rekordhoch. Die Erregerauswahl war somit adäquat, aber schwierig, mit Stämmen, die sich nicht in phänotypischer Bestform befanden.

N. persicolor (oben links), T. benhamiae (oben rechts). T. interdigitale (unten links), T. mentagrophytes (unten Mitte) und T. quinckeanum (unten rechts). Die Reihenfolge der Speziesangabe stimmt bewusst nicht mit der im Ringversuch überein.
Die gute Nachricht ist: Der Phänotyp kann täuschen, der Genotyp dagegen nicht. Gerettet hat mich folgerichtig, wie so oft auch in der täglichen Praxis, die PCR. Auch in diesem Punkt ist vieles besser als früher. „Alles raus bekommen“, lautete die Nachricht meiner Mitarbeiter auf dem Weg zum Pilzseminar nach Hannover. Stresstest bestanden (Abb. 1)!
Ich habe es grundsätzlich keine Sekunde bereut, mir die PCR angeeignet zu haben, weder fachlich noch wirtschaftlich. Sie ist eine wunderbare Methode zur rechten Zeit: schnell, präzise, unbestechlich, nicht in die Irre führend, wie manche Pilzkultur, und entspannend. Nun auch in einem schwierigen Ringversuch. Mein Rat ist daher mehr denn je: Leute, macht die PCR, auch im Alltag. Denn das Erregerspektrum der Mykosen wird immer bunter, reicher, exotischer und konventionell schwieriger zu bestimmen.
Ein Grummeln in der Dermatologenschaft wird nach diesem Ringversuch allerdings möglicherweise bleiben: Denn eine Kultur anzulegen ist immer noch besser als gar keine detaillierte Diagnostik. Alle Kolleginnen und Kollegen, die heldenhaft an der kulturellen Diagnostik festhalten, um die mykologische Grundversorgung der Bevölkerung abzusichern, seien erinnert, dass sie Bedenken über den Ringversuch an die Bundesärztekammer und Ringversuchsleitung weitergeben können. In deren RiliBÄK steht, dass der Ringversuch ein Abbild der täglichen Praxis sein soll. Diesen Eindruck konnte man angesichts eines äußerst seltenen N. persicolor und in der übersendeten Form kaum bestimmbarer weil degenerierter Trichophyton-Spezies nicht gewinnen.
Ein dieses Mal sehr nachdenklicher
Hans-Jürgen Tietz
Zehnter Beitrag der Artikelreihe: Moderne Mykologie in der Dermatologie